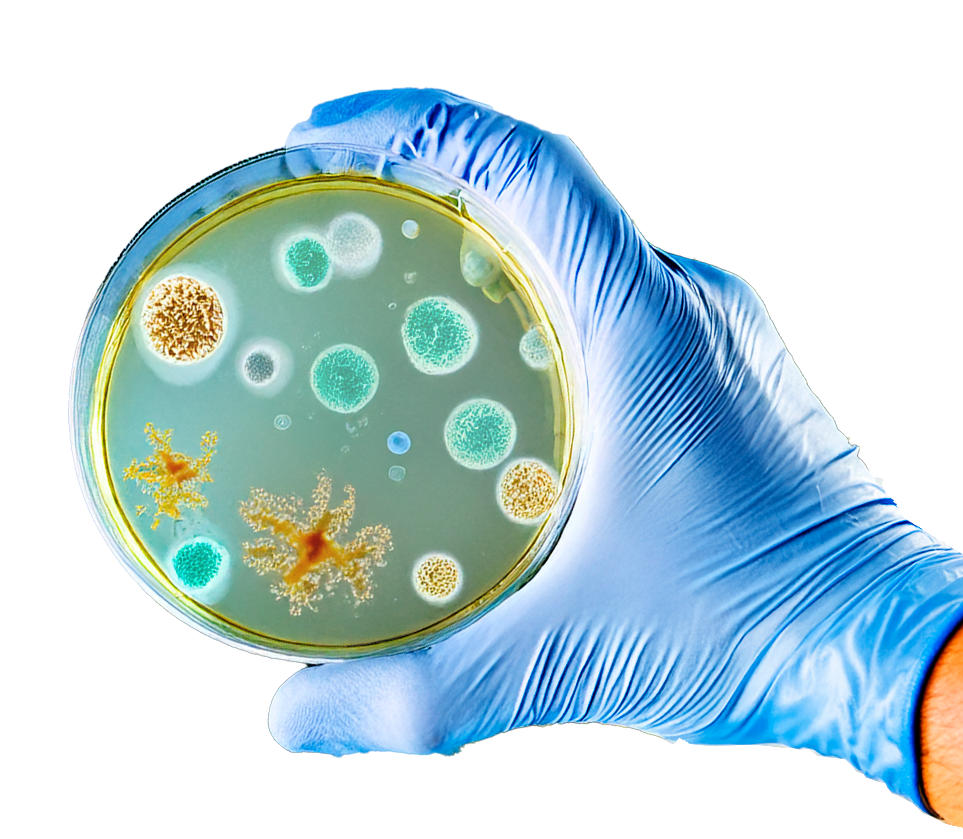

-
nAtive
Biorremediação Avançada
Desenvolvemos um processo patenteado
para restaurar ambientes contaminados
de forma natural e sustentável.nAtive
Biorremediação Avançada
Desenvolvemos um processo
patenteado para restaurar
ambientes contaminados de forma
natural e sustentável.
O que é o Processo nAtive?
Tecnologia exclusiva em processo de patente para regeneração ambiental
O nAtive é um processo biotecnológico exclusivo e patenteado pelo Grupo Nortnova, baseado na bioaumentação de microbiota nativa. Utilizamos microrganismos altamente especializados para acelerar a degradação de poluentes em águas, solos e efluentes industriais, promovendo a recuperação natural dos ecossistemas.
Diferenciais do nAtive
Tecnologia exclusiva em processo de patente
Utiliza microrganismos nativos, sem impactos negativos ao meio ambiente
Alta eficiência na degradação de poluentes complexos
Redução de custos operacionais em comparação a métodos convencionais
Aplicação customizada para diferentes tipos de contaminação
Como Funciona
Identificação e Análise
Coletamos amostras do ambiente contaminado e realizamos uma análise detalhada da microbiota existente.
Seleção e Bioaumentação
Selecionamos e multiplicamos os microrganismos mais eficientes para degradar os poluentes presentes.
Inoculação e Monitoramento
Aplicamos os microrganismos no ambiente e acompanhamos seu desempenho, garantindo a máxima eficácia.
Regeneração Completa
O processo de biorremediação transforma o ambiente, reduzindo contaminantes de forma sustentável.
Aplicações do nAtive
Porque Escolher nAtive
O nAtive é um marco na biotecnologia ambiental. Nossa solução patenteada é o resultado de anos de pesquisa do Grupo Nortnova, aliando inovação científica e compromisso com a regeneração do planeta.
Tecnologia exclusiva
Processo patenteado e desenvolvido internamente.
Solução 100% sustentável
Sem impacto ambiental negativo.
Redução de custos
Alternativa mais eficiente e econômica que métodos tradicionais.
Aplicação flexível
Adaptável para diversos setores industriais e ambientais.
Entre em Contato
Usamos cookies para proporcionar melhor desempenho e experiência de navegação. Ao continuar navegando neste site, você declara estar ciente dessas condições. Política de Privacidade Termos de Uso
